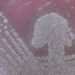

L’avion Solar Impulse, qui vit sa deuxième vie aux Etats-Unis, vient d’être utilisé pour le compte de l’armée américaine. Alors que son concepteur Bertrand Piccard avait juré du contraire lors de la vente de l’avion en 2019.
Dix ans tout juste après son tour du monde à succès, Solar Impulse vole à nouveau. Mais cette fois pour le compte de l’US Navy, l’armée de mer américaine. Il y a 5 ans, son inventeur, Bertrand Piccard, soulignait pourtant dans l’émission TTC, le 16 novembre 2020 : « Pour respecter nos valeurs, on a aussi un point précis dans le contrat que Solar Impulse n’est pas utilisé pour but militaire.»
Un virage assumé, mais contesté
Car quelques mois plus tôt, l’avion était vendu à une société hispano-américaine, Skydweller, pour le transformer en drone de surveillance (environnemental ou industriel) ou de télécommunication. Premier vol autonome en 2023, avec un pilote mais qui ne touchait plus les commandes. Puis vol sans pilote l’an dernier.
Puis viennent les tests financés par la marine américaine, annoncés fin juillet 2025 sur le site de la marine américaine, avec des objectifs bien définis: « Développer l’intelligence maritime, la surveillance et la reconnaissance ».
Pour Bertrand Piccard, aucune contradiction avec ce qu’il affirmait il y a cinq ans: «Vous savez, la marine américaine a des tas d’engagements qui ne sont pas des missions de combats et qui ne sont pas des missions militaires. Exactement comme le financement de la plongée à 11’000m de mon père en 1960 par la US Navy, c’était à but totalement civil, c’était le laboratoire de recherches de la Navy. Donc il ne faut pas croire que parce que c’est un organisme militaire, ça va être utilisé de manière militaire.»
Une collaboration scientifique justifiée
Mais pour Suren Erkman, professeur honoraire en écologie industrielle à l’Université de Lausanne et spécialiste des technologies renouvelables, qui a suivi le projet depuis ses débuts, l’argument ne tient pas : « Les militaires savent depuis longtemps qu’ils font encore plus progresser les questions de défense, en finançant aussi de la recherche ouverte et qui peut être vue comme civile. Mais derrière, il y a quand même toujours des retombées potentiellement pour la défense, des arrières pensées. Il n’y a rien de mal à cela, du reste, en principe. Mais pourquoi ne pas le dire? » « Mais Skydweller ne va pas utiliser Solar Impulse pour cela, rétorque Bertrand Piccard. Le but de Skydweller, c’est de montrer que c’est possible avec des instruments scientifiques à bord. Et ensuite de commercialiser une variante de Solar Impulse qui, elle, pourra être utilisé par n’importe qui. »
Car le marché des drones de haute altitude est en plein essor, comme l’explique Suren Erkman. Selon le spécialiste, ces appareils constituent une pièce stratégique dans les systèmes de communication liés dans le puzzle des systèmes d’armement – terrestre, marin et aérien –, un secteur largement porté par les investissements militaires.
Contactée, Skydweller n’a pas réagi.
Mais un autre point figure dans le contrat de vente de l’avion solaire : après ces tests, il devrait revenir en Suisse, au Musée des transports de Lucerne.